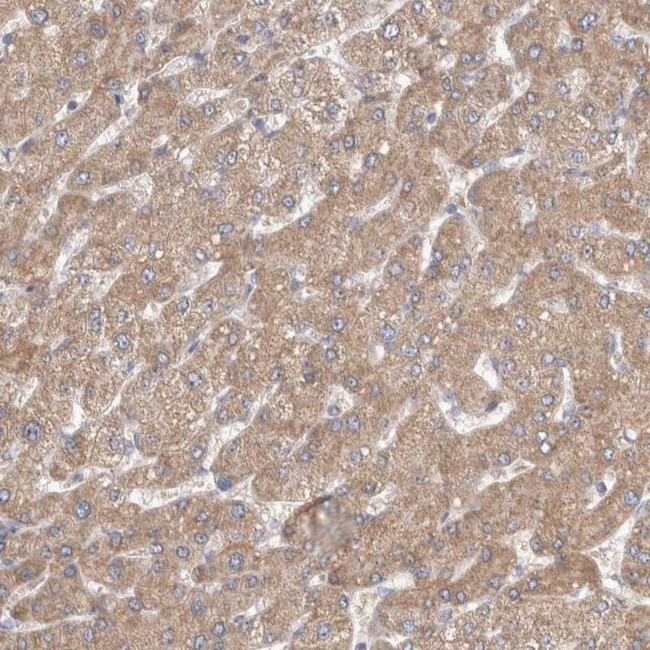
SCO1 Antibody in Immunohistochemistry (IHC)

Search
Invitrogen
SCO1 Polyclonal Antibody
{{$productOrderCtrl.translations['antibody.pdp.commerceCard.promotion.promotions']}}
{{$productOrderCtrl.translations['antibody.pdp.commerceCard.promotion.viewpromo']}}
{{$productOrderCtrl.translations['antibody.pdp.commerceCard.promotion.promocode']}}: {{promo.promoCode}} {{promo.promoTitle}} {{promo.promoDescription}}. {{$productOrderCtrl.translations['antibody.pdp.commerceCard.promotion.learnmore']}}






Please note: We are reviewing Western blot images included in the antibody testing data in our catalog, including those provided by third parties. Unless expressly labeled or annotated as “raw-unedited”, Western blot images included in the antibody testing data in our catalog may have been edited, optimized or otherwise adjusted for presentation.
产品信息
PA5-54452
种属反应
宿主/亚型
分类
类型
抗原
偶联物
形式
浓度
规格
纯化类型
保存液
内含物
保存条件
运输条件
RRID
产品详细信息
Immunogen sequence: TREEVDQVAR AYRVYYSPGP KDEDEDYIVD HTIIMYLIGP DGEFLDYFGQ NKRKGEIAAS IATHMRPYR
Highest antigen sequence identity to the following orthologs: Mouse - 86%, Rat - 86%.
靶标信息
Synthesis of cytochrome c oxidase 1 was initially identified in yeast as one of two cytochrome c oxidase (COX) assembly proteins that enable the assembly of cytochrome c holoenzyme, a complex that catalyzes the transfer of reducing equivalents from cytochrome c to molecular oxygen and pumps protons across the inner mitochondrial membrane. Like their yeast homologs, the function of both SCO1 and SCO2 are dependent on copper ion binding. Mutations in either gene can lead to cytochrome c oxidase respiratory chain defects, with a missense mutation in human SCO1 (P174L) associated with a fatal neonatal hepatopathy when the second allele is also non-functional, suggesting the pathology is due to loss of function. It has been suggested that this mutation alters the SCO1 affinity for the copper (I) ion, thus impairing the efficiency of copper transfer to the cytochrome c oxidase.
仅用于科研。不用于诊断过程。未经明确授权不得转售。